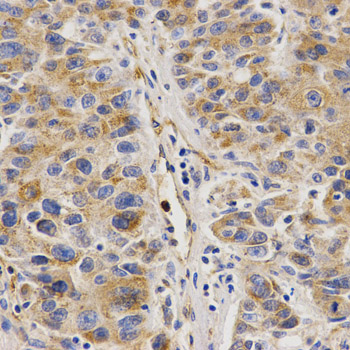

Anti-VAPB Antibody
A30756
ApplicationsImmunoFluorescence, Western Blot, ImmunoHistoChemistry
Product group Antibodies
ReactivityHuman, Mouse, Rat
Overview
- SupplierAntibodies.com
- Product NameAnti-VAPB Antibody
- Delivery Days Customer7
- ApplicationsImmunoFluorescence, Western Blot, ImmunoHistoChemistry
- CertificationResearch Use Only
- ClonalityPolyclonal
- ConjugateUnconjugated
- Estimated Purity>95%
- HostRabbit
- Scientific DescriptionRabbit polyclonal antibody to VAPB
- ReactivityHuman, Mouse, Rat
- UNSPSC12352203

![VAPB antibody detects VAPB protein by immunofluorescent analysis. Sample: DIV9 rat E18 primary cortical neuron cells were fixed in 4% paraformaldehyde at RT for 15 min. Green: VAPB stained by VAPB antibody (GTX131631) diluted at 1:500. Red: Tau, stained by Tau antibody [GT287] (GTX634809) diluted at 1:500. Blue: Fluoroshield with DAPI (GTX30920).](https://www.genetex.com/upload/website/prouct_img/normal/GTX131631/GTX131631_43103_20190306_ICC_IF_R_w_23060523_830.webp)
